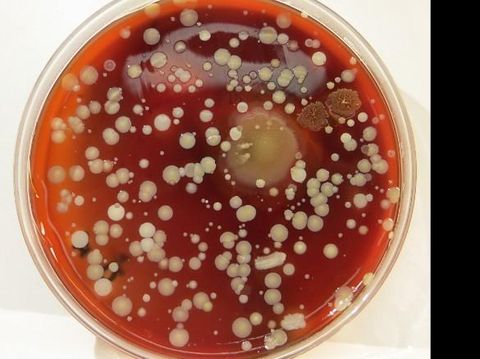
Ilustrasi bakteri

Kuman super yang kebal antibiotik tersebut dikirim bersama roket SpaceX Falcon 9. Selanjutnya kuman itu akan diteliti oleh astronot di Stasiun Luar Angkasa Internasional. Demikian diwartakan CNN.
Ketua tim peneliti, Dr Anita Goel, menuturkan tujuan pengiriman bakteri super ke luar angkasa. Jadi di luar angkasa yang tanpa gravitasi, ilmuwan akan lebih memahami bagaimana bakteri bermutasi sehingga menjadi kebal terhadap antibiotik.
ADVERTISEMENT
SCROLL TO CONTINUE WITH CONTENT
Diketahui di gravitasi nol ataupun mikrograviti membuat jamur tumbuh lebih cepat. Untuk itu peneliti ingin pula mengetahui apakah gravitasi nol, radiasi elektromagnetik dan elemen tak terduga lainnya akan bekerja dengan cara yang sama bagi bakteri. Intinya peneliti ingin tahu apakah kondisi lingkungan juga berpengaruh pada DNA bakteri.
Nah, jenis bakteri yang dikirim ke luar angkasa adalah Methicillin-resistant Staphylococcus aureus (MRSA). Bakteri ini diketahui bisa menyebabkan masalah kesehatan seperti sepsis, pneumonia, serta infeksi kulit dan aliran darah. Dalam beberapa kasus, bakteri ini diketahui resisten terhadap antibiotik methicillin dan lainnya.
Ilustrasi bakteri Foto: CNN Ilustrasi bakteri Foto: CNN |
"Saya memiliki hipotesis bahwa mikrograviti akan mempercepat pola mutasi," ucap Goel.
Baca juga: Seram! Begini Kondisi Dunia Bila Semua Bakteri Kebal Obat
Jika mikrograviti di stasiun luar angkasa bisa digunakan sebagai akselerator untuk melihat seperti apa mutasi yang terjadi, maka diharapkan bisa dikembangkan obat yang lebih ampuh bagi penduduk Bumi. Obat tersebut diharapkan bisa lebih personal dan lebih tepat sasaran untuk mengatasi kuman penyebab penyakit.
"Kita bisa memiliki obat-obatan pintar yang siap sebelum mutasi muncul di Bumi," imbuh Goel sembari menambahkan bakteri dibawa dengan cara yang aman sehingga bisa diteliti dengan optimal tanpa menyebabkan gangguan.
Goel merupakan seorang dokter medis dan ahli fisika. Dia juga CEO dari Nanobiosym yang menggabungkan fisika, biomedis dan nanoteknologi untuk mencari terobosan yang bermanfaat bagi dunia medis dan fisika.
Menurutnya melakukan penelitian di stasiun luar angkasa bisa menjadi cara baru berpikir menggunakan perspektif yang berbeda. "Jika kita melakukannya, kita belajar hal baru dan menemukan cara baru untuk melihat hal-hal yang sudah ada maupun data yang sudah lama," imbuh Goel.
Baca juga: Ketika Belum Ada Antibiotik, Cara-cara Ini Dipakai untuk Lawan Infeksi
(vit/mrs)




















































